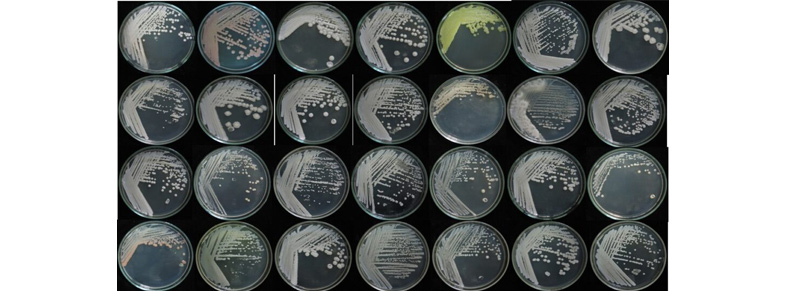

“Organic Fertilizer from Cassava Waste” An Innovation from Chula to Replace Chemical Fertilizers and Increase the Value of Agricultural Waste
Sponsored by

Sponsored by

A Chula researcher has been successful in adding value to agricultural waste generated by industrial factories by transforming cassava waste and sewage sludge into organic fertilizer to replace the use of chemical fertilizers. He has also come up with a special formula of microbial inoculum that increases nutrients needed by plants.
Cassava is a vital agricultural product that has been a driving force for the Thai economy. In 2021, for example, the country produced as much as 30 million tonnes of cassava and has ranked third in the world as producer of cassava. With such huge volumes of production, it isn’t surprising that the waste found in industrial factories producing tapioca starch would also be enormous. Each year there are at least 12 million tonnes of cassava that need to be appropriately managed along with the sewage sludge being disposed of in a way that doesn’t contribute to causing pollution as well as a negative impact to the environment.

Professor Dr. Warawut Chulalaksananukul
Department of Botany, Faculty of Science
Chulalongkorn University
Realizing this crucial problem, Professor Dr. Warawut Chulalaksananukul of the Department of Botany, Faculty of Science, Chulalongkorn University has come up with the idea to increase the value of agricultural waste in ways that are beneficial to the environment and the food chain through the research entitled “Production of organic fertilizer from waste generated by the cassava starch industry with a combination formula of microbial inoculum.”
“Cassava waste can be used for animal feed and those that are left over from serving the needs within the country are exported to foreign countries. But the surplus levels making the cassava waste exceeding the needs of the market have driven the prices down significantly” Prof. Dr. Warawut described the situation and the problem that brought about this research work.
“As for the sewage sludge that comes from the water treatment system involved in the production of tapioca starch, once it gets discarded or destroyed by way of burning, burying, or turning into fertilizer the sludge might contain microorganisms that cause disease in plants as well as the heavy metals contamination.”
Tapioca starch is suitable for producing organic fertilizer
The main components of cellulose, starch, fiber, and protein all contribute to the growth of plants. Moreover, the structure of cassava waste is such that it appears porous and is therefore highly water absorbent, providing good drainage, and preventing the roots from rotting.
The sewage sludge from tapioca starch factories contains organic materials that plants can utilize though they need to go through grinding and fermentation processes first.
Transforming cassava waste and sewage sludge into compost and organic fertilizer is therefore another option to reduce pollution and its impact on the environment.
Special microbial inoculum blend that increases essential nutrients for plants.
Prof. Dr. Warawut added that even though cassava is rich in various nutrients needed for plants to grow, that is still not enough. Plants also require main nutrients like nitrogen, phosphorus, and potassium as well as secondary nutrients like calcium and magnesium and supplementary nutrients like manganese, copper, iron, and zinc.
Therefore, in the process of turning cassava waste into organic fertilizer, some of the nutrients need to be added to the special formula of microbial inoculum being invented.
The process of turning cassava waste and sewage sludge into organic fertilizer starts with the preparation of the initial substance followed by additives and finally coated with the special formula of microbial inoculum and left to ferment for two months.
“These microbes belong to the group of bacteria that is considered safe for humans and the environment. They can decompose both types of initial substances and keep the nitrogen that has direct benefits to plants.”
In the future, Prof. Dr. Warawut is aiming to extend the research to develop microbial inoculum from other types of agricultural and industrial waste.
Readiness for production to serve commercial purposes
The research project has experimented with the use of organic fertilizer for cassava planted in Sikhio District, Nakhon Ratchasima Province and the results have been satisfactory.
Prof. Dr. Warawut explained that the fertilizer that has been produced contributes well to the growth of the plants under the standards of organic fertilizers. Incidentally, it has also been found that cyanide found in cassava waste that has undergone the fermentation process is at an extremely low level it can hardly be detected.
“The fertilizer we have produced from cassava waste can be used with all types of plants, especially for crops like cassava, rice, sugar cane, or corn. It enables us to reduce the use of chemical fertilizers that have long-term effects on soil quality. It also helps reduce toxins generated by various forms of waste management such as burning.” Prof. Dr. Warawut concluded. He also added that Thai Wah Public Company Limited has been instrumental in providing research funding for the project.
Agriculturists and individuals interested in this innovation may contact Prof. Dr. Warawut Chulalaksananukul at the Department of Botany, Faculty of Science, Chulalongkorn University at telephone number +66-2218-5482 or via E-mail: warawut.c@chula.ac.th